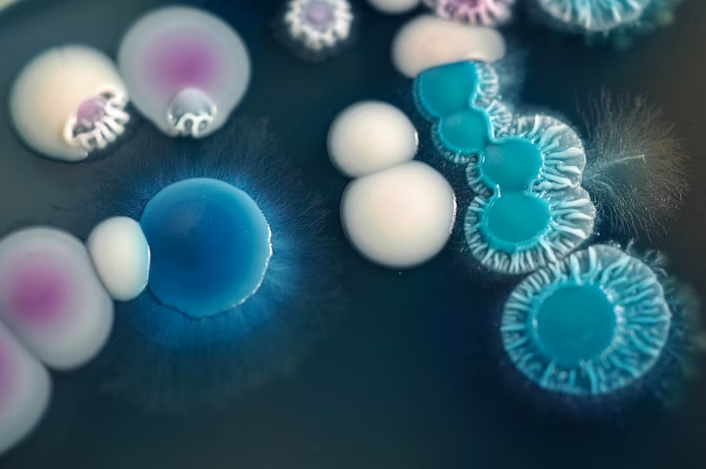

An imbalance of microorganisms in the human body is often the result of changes in internal conditions that favor the growth of certain species, including Candida. When these conditions are disrupted, it can lead to its uncontrolled multiplication, which may be the beginning of various health problems.
Why does Candida overgrow in the body?
One of the most common causes of candidiasis is excessive and improper use of antibiotics. Their effect does not only target harmful bacteria, but also disrupts the beneficial intestinal flora, creating an environment suitable for fungal growth.
Such a condition in the body can be compared to climate conditions in nature—warm and humid environments promote the growth of fungi, while shifts toward drier and more stable conditions limit their development. A similar principle applies to the human body.
Types of candidiasis: Where does Candida most commonly develop?
Depending on the location of its overgrowth, candidiasis can appear in several forms:
- Oral candidiasis affects the mouth and tongue
- Vaginal candidiasis is common in women and is accompanied by unpleasant symptoms
- Urinary tract infection, when Candida causes issues in the urinary system
- Intestinal candidiasis affects digestion and the digestive system
- Systemic candidiasis is the most severe form, potentially dangerous because it affects the entire body and can lead to serious complications
How is Candida treated?
The standard approach involves the use of antifungal medications, which specifically target fungi. Depending on the location and severity of the infection, treatment can be local or systemic.
Milder forms are treated with local preparations, while more serious infections require therapy that affects the whole body. Probiotics are often recommended as support, as they help restore healthy microflora.
Although alternative approaches are popular, it is important to emphasize that there is no clear scientific evidence that they can eliminate Candida on their own. They may serve as additional support, but not as a replacement for proper medical treatment.
Probiotics and prebiotics: The key to balance
Probiotics are beneficial microorganisms that play an important role in maintaining gut health and immunity. Regular consumption of fermented foods or supplements can significantly help stabilize microflora.
Prebiotics, on the other hand, are fibers that feed beneficial bacteria. They are found in foods such as garlic, onions, leeks, asparagus, legumes, berries, and green bananas.
Their combination with probiotics can be powerful support for the body in combating imbalance.
Natural allies alongside therapy
Certain natural ingredients may be useful as a complement to therapy. These include coconut and olive oil (oleic acid), capsules with oregano or thyme oil, and garlic.
These ingredients may help control fungal growth, but they should be used carefully and in appropriate forms.
Diet as an important factor
Changing dietary habits can often be an important step in controlling candidiasis. It is recommended to temporarily eliminate sugar, white flour, and most dairy products.
The focus should be on a balanced diet that supports healthy microflora. Some data suggest that certain sweeteners may influence Candida growth, but further research is needed.
Alcohol and smoking – hidden triggers
Alcohol consumption may be associated with increased fungal growth in the body, while smoking further disrupts the balance of microorganisms, especially in the oral cavity.
Therefore, avoiding these habits during treatment is recommended, as they may hinder recovery.
Consequences of improper treatment
Improper or prolonged treatment of microorganisms may be associated with additional strain on the body. Some studies suggest that persistent use of certain therapies may be linked to the development of various health conditions, including digestive disorders and even changes in mental functioning.
For this reason, experts emphasize the importance of a comprehensive approach—understanding the causes, not just the symptoms.